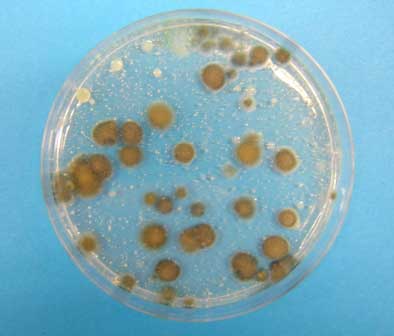

Consulenze
Consulenza ed assistenza tecnica per ridurre l'impatto ambientale nei processi industriali, per le bonifiche, per il recupero di aree inquinate, per la rivalorizzazione degli scarti industriali, ecc...
Sistemi
- Bio-generatori
- Bio-reattori
- Bio-filtri
- Sistemi di trattamento reflui gassosi
- Sistemi di abbattimento emissioni maleolente
- Dosatori automatici
Servizi
- fornisce un servizio di consulenza tecnica ed assistenza nella scelta dei prodotti migliori per il raggiungimento di uno specifico obiettivo, permettendo alle aziende clienti di ottenere soluzioni ottimali
|
|
- grazie al proprio laboratorio di ricerca e sviluppo, esegue analisi chimiche e microbiologiche, comprese analisi fitopatologiche su vegetali ed analisi microbiologiche su terreni, proponendo le soluzioni più adeguate per la risoluzione delle problematiche che possono interessare l’ambiente, l’industria, l’agricoltura, le comunità, gli impianti di trattamento acque reflue, ecc.
|
|
La particolare attenzione alle esigenze dei propri clienti e la rapidità nelle consegne completano l’elevata qualità del servizio offerto dalla N.T.I.